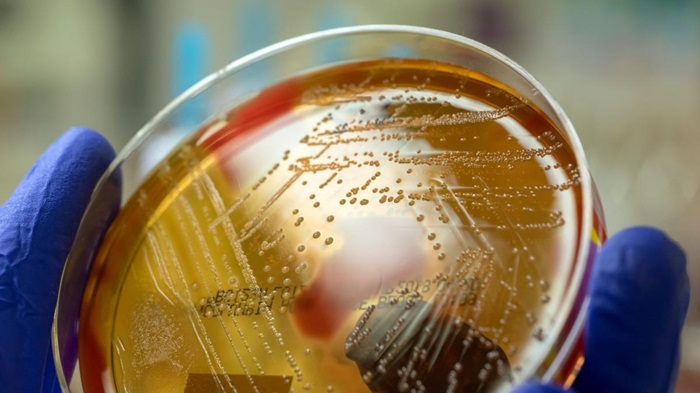

Bacteria estreptococo cimbró a Japón y ya le llaman “la enfermedad carnívora”
marzo 20, 2024
En los últimos días, Japón ha detectado una infección que se propaga a un ritmo récord y tiene que ver con la bacteria estreptococo.
De acuerdo con sdpnoticias, si bien esta infección bacteriana ya había sido detectada en Japón desde hace treinta años, ahora preocupa a autoridades sanitarias por los contagios activos.
“Hay más casos que nunca”, mencionan medios locales acerca del Síndrome de Shock Tóxico Estreptocócico (STSS).
Las autoridades sanitarias de Japón están en alerta roja por la velocidad de propagación de la bacteria estreptococo.
De acuerdo con medios locales, “hay más casos que nunca” del Síndrome de Shock Estreptocócico, causado por la bacteria estreptococo del grupo A.
Según datos del Instituto Nacional de Enfermedades Infecciones, la bacteria estreptococo ha aumentado su propagación de manera preocupante desde el 2023.
En 2019 se superó la cifra de 894 casos activos y en 2023 alcanzó 941; en los primeros meses de 2024, se registran 378.
Las infecciones por la bacteria estreptococo se han detectado en 45 de las 47 prefecturas de Japón.
De momento, las autoridades sanitarias instan a la población a adoptar medidas preventivas de higiene; como lavarse las manos y cuidar las heridas.
Ante el aumento de casos activos de infecciones por la bacteria estreptococo en Japón, aún se desconoce la causa exacta.
El ministro de Sanidad de Japón, Keizo Takemi, sugirió que probablemente estaba relacionado con el repunte de las enfermedades respiratorias.
Esto, después de que Japón entrara en una fase pospandémica del Covid-19 en la primavera del 2023.
Por su parte, la Organización Mundial de la Salud refiere que el aumento de casos de infecciones por bacteria estreptococo sólo está ocurriendo en Japón.
Sin embargo, en diciembre de 2022, la OMS notificó un incremento histórico de las infecciones pediátricas por la bacteria estroptococo. Específicamente en:
Francia
Irlanda
Países Bajos
Suecia
Reino Unido
Irlanda del Norte
Estados Unidos
La mayoría de las personas con infección por bacteria estreptococo, desarrollan síntomas en vías respiratorias y cutáneas.
La enfermedad suele causar enfermedades leves como amigdalitis, faringitis, celulitis y escarlatina.
La bacteria estreptococo del grupo A puede presentarse en la garganta o la piel de la persona.
El contagio se produce por contacto estrecho con una persona infectada y puede transmitirse a través de la tos, estornudos o el contacto con una herida.
Se sabe que la tasa de mortalidad de una infección por bacteria estreptococo es del 30%, según instituciones japonesas.
Las infecciones por bacteria estroptococo a menudo han sido apodadas como la “enfermedad carnívora”.
Ya que puede causar necrosis de los tejidos conectivos que cubren los músculos en casos graves.
Ahora que la bacteria estreptococo ha aumentado en Japón, el apodo de “enfermedad carnívora” también resurge entre medios.












